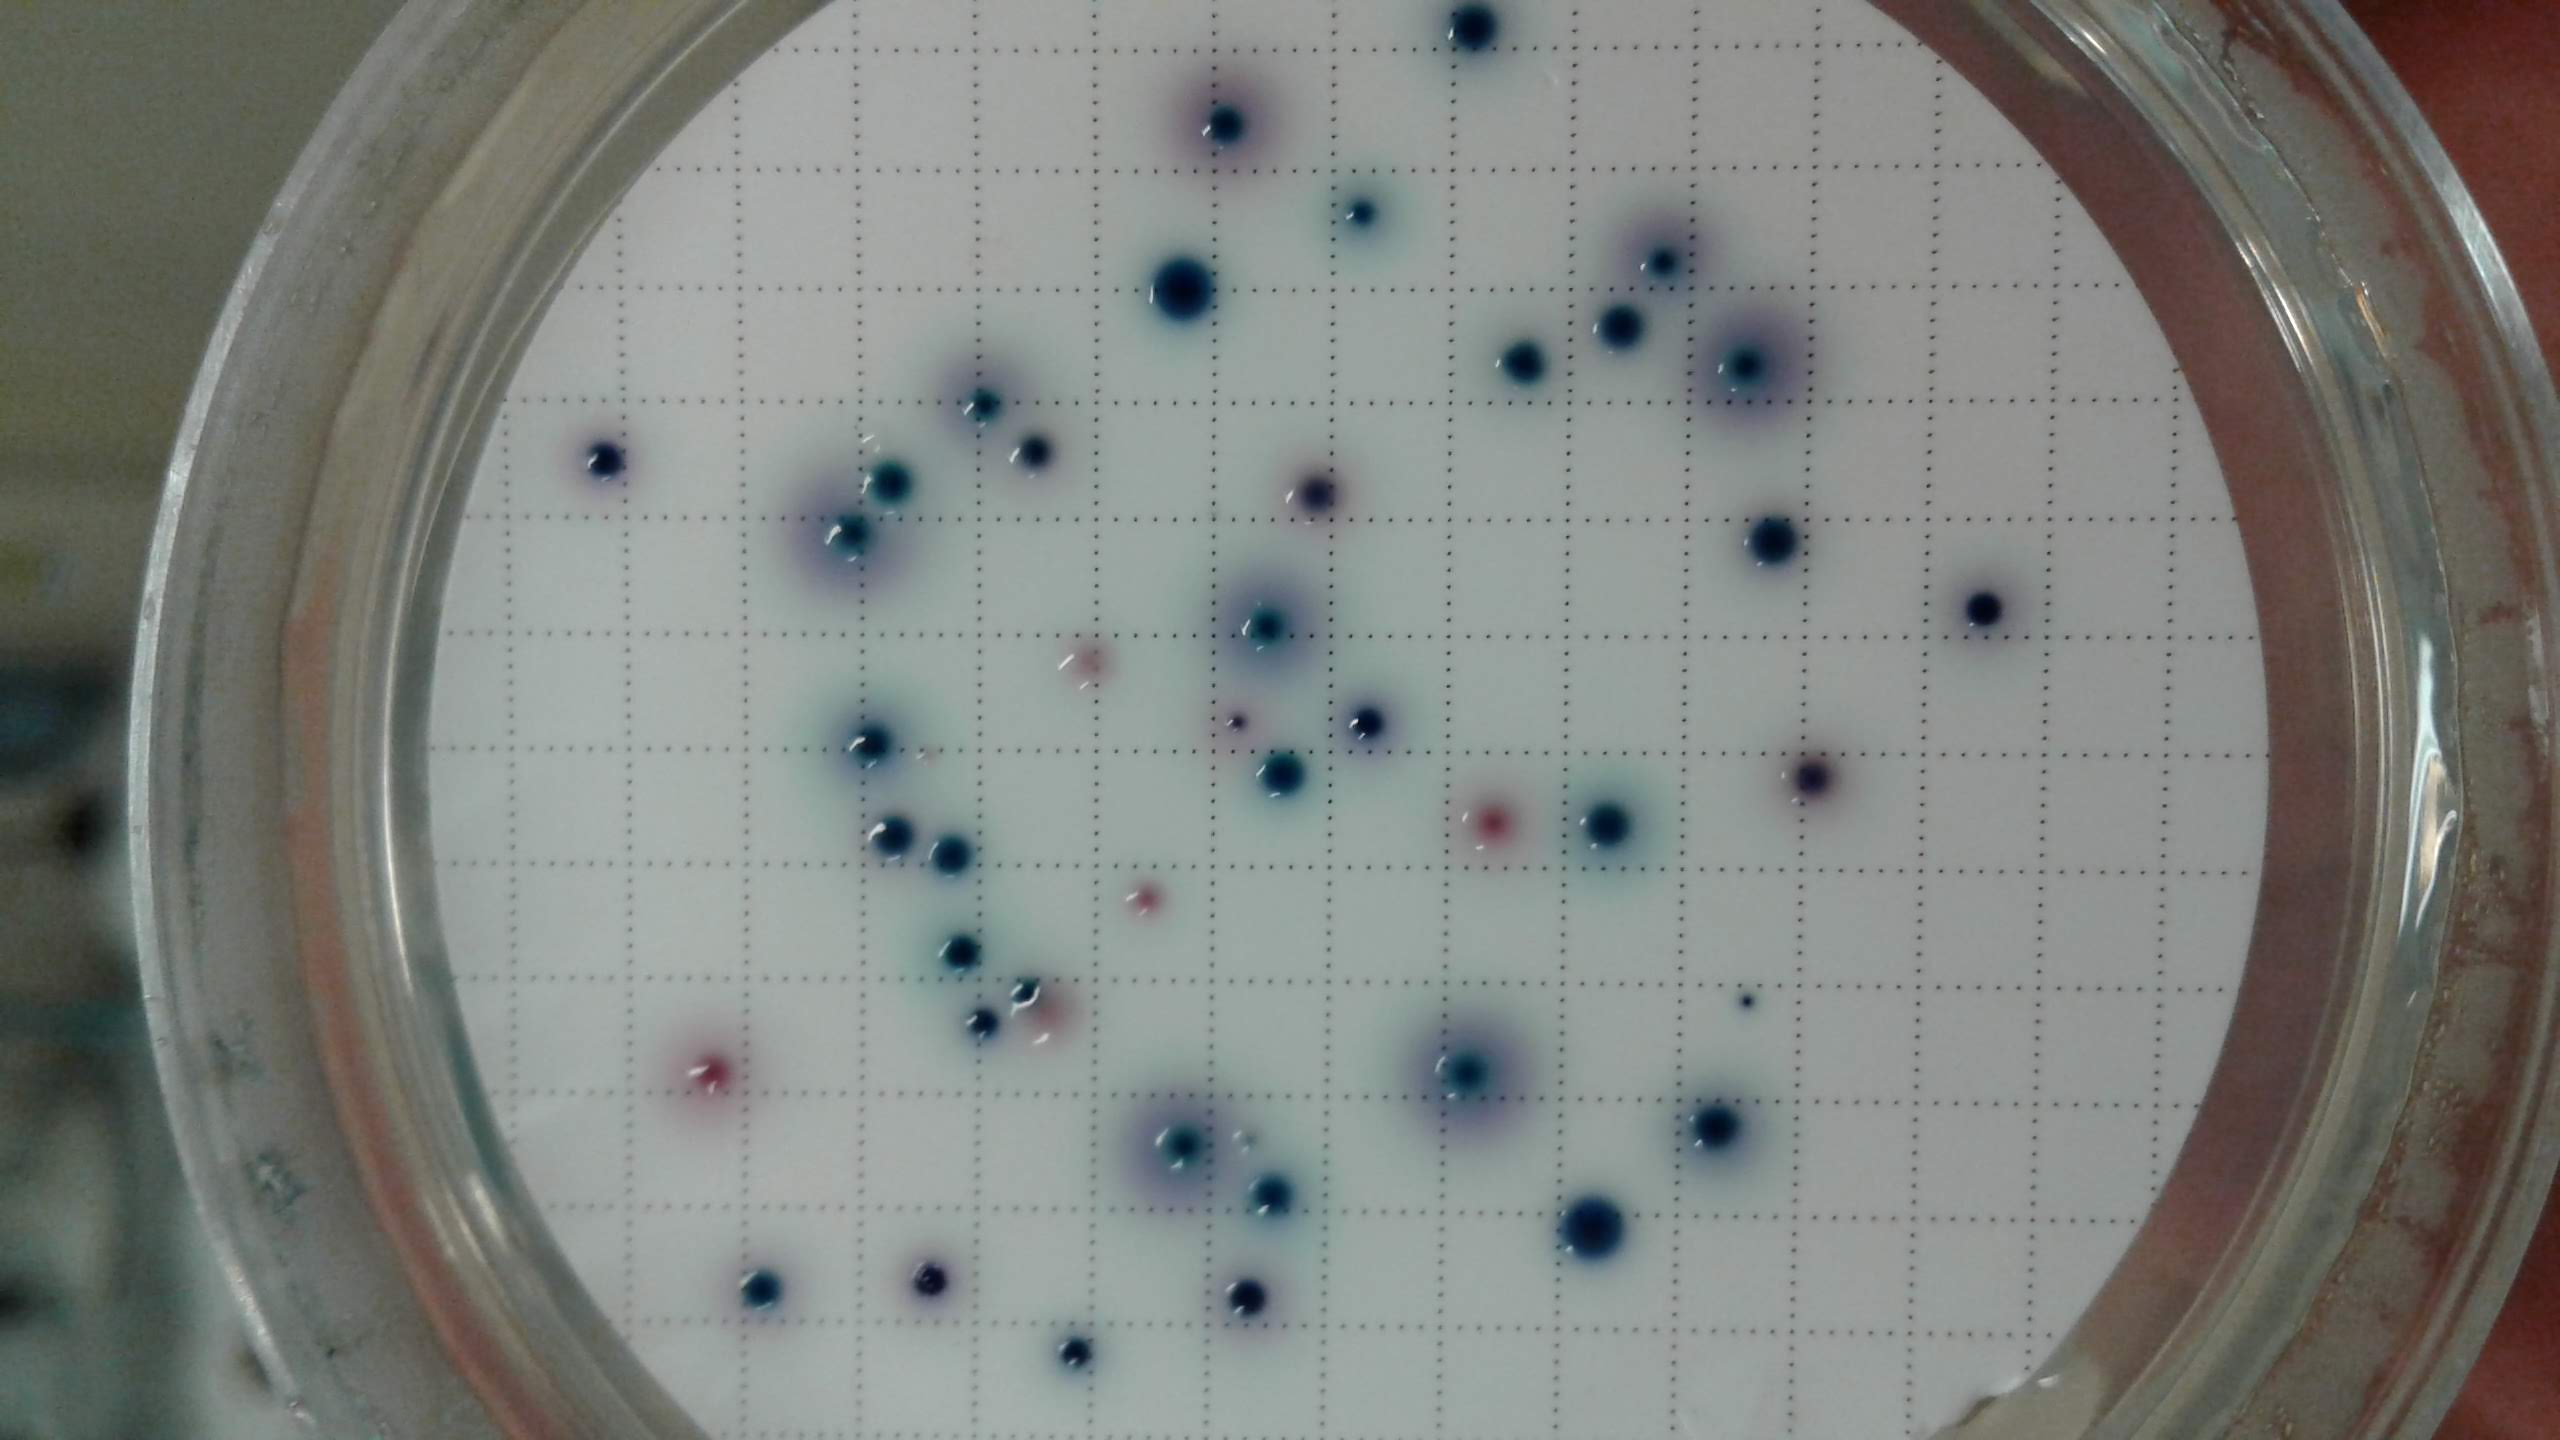
2018 E coli e coliformi lab micro

Le analisi microbiologiche dell'acqua. Di che si tratta?
L'analisi microbiologica dell'acqua è un processo di valutazione della qualità dell'acqua per identificare la presenza e/o la quantità di microrganismi (come batteri e virus).
ARPA Valle d'Aosta, in quanto ente strumentale della Regione Valle d'Aosta, supporta le attività di monitoraggio ambientale fornendo dati affidabili e oggettivi, fondamentali per orientare le decisioni istituzionali.
Per supportare le attività di controllo stabilite dall'Azienda USL della Valle d'Aosta e per contribuire al monitoraggio dello stato dei corpi idrici nella regione Valle d’Aosta, il laboratorio dell’Area Operativa Biologia, microbiologia e virologia esegue periodicamente analisi microbiologiche su diverse fonti d’acqua tra cui:
- Acque di fontanili: risorse locali preziose che necessitano di controlli periodici per garantirne la salubrità.
- Acque di sorgente: per preservare la qualità e la purezza delle acque fin dalla loro origine.
- Acque minerali imbottigliate: per assicurare che i prodotti che arrivano sulle nostre tavole siano sicuri.
- Acque microfiltrate: come quelle fornite dalle “case dell’acqua” pubbliche, per garantirne la sicurezza.
- Acque superficiali: provenienti da fiumi e corsi d’acqua, come la Dora Baltea, per monitorare la salute degli ecosistemi acquatici e prevenire il degrado ambientale.
- Acque reflue: derivanti da scarichi domestici o industriali, per verificare che vengano trattate correttamente e non rappresentino una minaccia per l’ambiente.
- Acque da impianti di distribuzione interni: come quelle dei rubinetti e delle docce, per garantire che l'acqua che arriva negli edifici sia sicura e conforme agli standard di qualità.
- Acque di piscina: per assicurare condizioni igieniche ottimali e la salute dei bagnanti.

Rampa di filtrazione

Analisi delle acque
Quali sono i microrganismi che ricerchiamo?
I microrganismi ricercati possono essere indicatori di contaminazione biologica o patogeni potenzialmente pericolosi per la salute umana. Una normativa specifica per ciascun tipo di acqua da analizzare stabilisce le specie microbiche da ricercare e le tecniche analitiche da utilizzare.
Alcuni esempi di microrganismi da noi ricercati nelle acque sono:
- Batteri fecali (Escherichia coli, Enterococchi): presenti naturalmente nell’intestino di esseri umani e animali, questi batteri sono indicativi di contaminazione fecale dell’acqua e la loro presenza segnala che l'acqua potrebbe contenere altri microrganismi patogeni (ovvero causanti malattie) pericolosi, rendendola un rischio per la salute e possibile causa di infezioni gastrointestinali.
- Batteri resistenti (Clostridium perfringens): questo batterio può produrre spore, una forma dormiente e altamente resistente che permette ai batteri di sopravvivere anche in condizioni difficili, come in presenza di disinfettanti, la sua rilevazione indica una possibile contaminazione di lunga durata o inefficacia dei trattamenti di disinfezione.
- Batteri opportunisti (Pseudomonas aeruginosa, Staphylococcus aureus): comuni nell’ambiente, questi batteri, pur non provenendo dall’intestino, possono diventare pericolosi in determinate condizioni, soprattutto per persone con sistema immunitario debole, causando infezioni se entrano in contatto con la pelle, soprattutto attraverso ferite.
- Legionella pneumophila: questo batterio prolifera in tubature e impianti di climatizzazione e può causare una grave infezione polmonare, è monitorato soprattutto in strutture collettive come alberghi e ospedali, dove il rischio di esposizione è più alto.
L'acqua che risulta contaminata da questi o altri batteri può rappresentare un rischio per la salute, specialmente per le persone più vulnerabili come bambini, anziani e persone con sistema immunitario indebolito.
Escherichia coli e coliformi
Cosa succede se l’acqua non è conforme?
Il laboratorio dell’Area Operativa Biologia, microbiologia e virologia esegue le analisi definite dall'Azienda USL della Valle d'Aosta e i risultati sono trasmessi agli uffici competenti, come il Dipartimento di Prevenzione dell'Azienda USL, i quali hanno la responsabilità di interpretare i dati e decidere eventuali misure o interventi per la tutela della salute pubblica e dell'ambiente, queste misure possono includere:
- Sospensione temporanea dell’erogazione dell’acqua: per evitare il consumo di acqua potenzialmente pericolosa.
- Restrizioni d’uso: come il divieto di utilizzo diretto o l’obbligo di bollitura prima dell’uso.
- Interventi correttivi: quali la sanificazione delle reti idriche o la bonifica delle fonti contaminate.
- Comunicazioni pubbliche: per informare i cittadini e fornire indicazioni precise su come comportarsi.
- Monitoraggi aggiuntivi: per verificare l’efficacia delle misure adottate e garantire un rapido ritorno alla conformità.
Perché è importante l'analisi microbiologica?
L'analisi microbiologica dell'acqua è fondamentale per:
- Garantire la sicurezza sanitaria: rileva microrganismi indicatori di un potenziale inquinamento della risorsa idrica, contribuendo a prevenire rischi per la salute pubblica.
- Assicurare il rispetto delle normative: verifica che l'acqua rispetti gli standard di qualità stabiliti dalla legge.
- Proteggere l’ambiente: previene l'inquinamento delle risorse idriche e tutela gli ecosistemi acquatici.
- Ultimo aggiornamento il .
- Visite: 815
